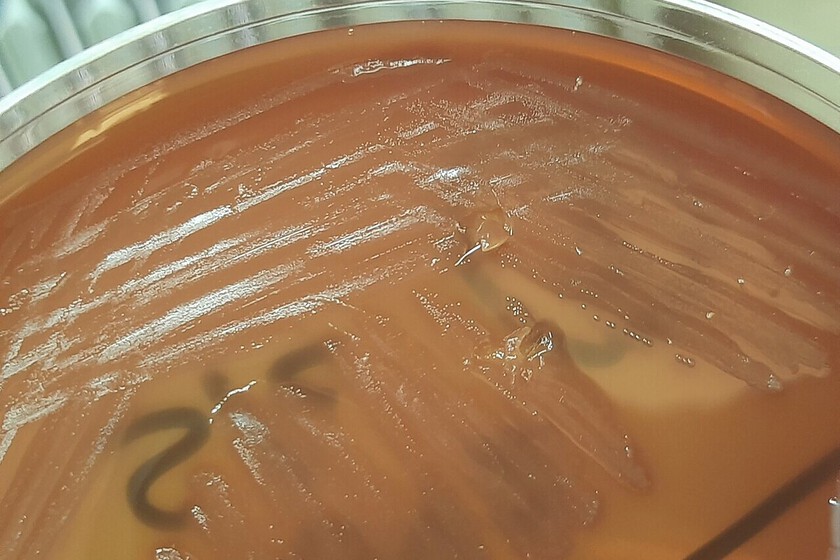

Cuando tratamos de definir la vida a menudo pensamos en los virus, esos organismos con algunas características de los seres vivos que no terminan de serlo del todo. Ahora puede que hayamos descubierto otro organismo en esa linde de la vida: los obeliscos.
Tras la pista del obelisco. Hace unos meses un equipo científico anunciaba un extraño hallazgo: restos genéticos de un organismo desconocido hasta ahora. Y lo hacía nada menos que al estudiar el microbioma del sistema digestivo humano.
Las secuencias de material genético son cadenas de ARN simétricas y alargadas, con forma de bastón. De ahí el nombre que se ha elegido para ellas, obelisco. Se trata sin embargo de cadenas genéticas cortas, de unos 1.000 nucleótidos de longitud.
Entre virus y viroides. Esto hace a los obeliscos muy sencillos, más que los virus. Estos últimos son capaces de codificar proteínas que encapsulan el material genético para darles el aspecto de una célula más. El obelisco sin embargo no tendría más que su información genética, que habitaría y se reproduciría en el interior de algunas bacterias.
Esta ausencia de una “capa” externa los asemeja a otro organismo en la linde entre la vida y la nada, los viroides. Estos viroides son cadenas genéticas no codificantes (no fabrican proteínas en sí mismas), sino que interactúan con el genoma celular de las plantas. El ARN de los obeliscos, en cambio sí podría codificar algunas proteínas.
Nuestros inquilinos. Los primeros estudios indican que estos organismos serían relativamente prevalentes en el microbioma humano: alrededor del 10% de las muestras analizadas encontraban indicios de estos organismos. En una de las bases de datos estudiadas por el equipo, la cual contenía muestras del microbioma oral de los participantes, cerca del 50% de las muestras contenían este material genético.
Además de la boca, estos obeliscos también han sido hallados en otras zonas del tracto gastrointestinal humano. Se intuye que distintos tipos de obelisco pueden encontrarse en los distintos “ecosistemas” microbianos. El equipo lleva identificadas casi 30.000 secuencias, cada una de las cuales podría ser clasificada como un tipo de obelisco.
Colonizando las bacterias. El siguiente paso era encontrar esta información genética en su huésped primario, las bacterias. Los obeliscos parecen haber “colonizado” nuestro microbioma a través de las bacterias.
Y el equipo encontró su rastro en una bacteria, de la especie Streptococcus sanguinis. Estas bacterias son comunes en nuestras bocas. El equipo analizó esta bacteria y encontró información genética correspondiente a un obelisco: una secuencia de ARN de 1.137 nucleótidos de longitud.
Obeliscos y oblinas. La información genética puede entenderse como un mecanismo de producción de proteínas. A las proteínas codificadas por estos genes se las ha denominado oblinas (oblins). Sabemos, como se ha dicho antes, que estas proteínas no se utilizan para encapsular la información genética de este organismo, pero aún es más lo que no sabemos de estas proteínas de las que se conocen ya dos tipos (Oblinas 1 y 2).
Mucho por investigar. Estos hallazgos aún se encuentran en proceso de discusión en el entorno científico. Por ahora no han sido publicados en ninguna revista pero los borradores del artículo se encuentran disponibles para quien desee consultar los detalles en el repositorio BiorXiv.
Si se confirman estos hallazgos, podríamos comprender mejor la evolución de los virus y, especialmente, de los viroides. Hasta ahora creíamos que estos últimos solo infectaban a plantas. Sin embargo, haber encontrado un organismo semejante, oculto a plena vista en nuestro propio micorobioma hace intuir que aún es mucho lo que tenemos que aprender de nuestra propia vida interna.
En Xataka | Un ecosistema con piernas: cómo los humanos hemos pasado de individuos a convertirnos en “holobiontes”
Imagen | Cultivo de Streptococcus sanguinis. Ajay Kumar Chaurasiya




